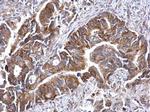
ATG16L1 Antibody in Immunohistochemistry (Paraffin) (IHC (P))

Search
Invitrogen
ATG16L1 Polyclonal Antibody
{{$productOrderCtrl.translations['antibody.pdp.commerceCard.promotion.promotions']}}
{{$productOrderCtrl.translations['antibody.pdp.commerceCard.promotion.viewpromo']}}
{{$productOrderCtrl.translations['antibody.pdp.commerceCard.promotion.promocode']}}: {{promo.promoCode}} {{promo.promoTitle}} {{promo.promoDescription}}. {{$productOrderCtrl.translations['antibody.pdp.commerceCard.promotion.learnmore']}}
图: 1 / 4
ATG16L1 Antibody (PA5-85542) in ICC/IF

产品信息
PA5-85542
种属反应
宿主/亚型
分类
类型
抗原
偶联物
形式
浓度
规格
纯化类型
保存液
内含物
保存条件
运输条件
RRID
产品详细信息
Keep as concentrated solution.
Predicted reactivity: Mouse (91%), Rat (93%), Pig (92%), Rhesus Monkey (80%), Bovine (94%).
Positive Control: MEF.
Store product as a concentrated solution. Centrifuge briefly prior to opening the vial.
靶标信息
Autophagy related protein 16 L is encoded by the ATG16L gene and is located on chromosome 2 in humans. It is also known as WD30 or IBD10 (Inflammatory Bowel Disease 10). ATG 12 and ATG5 conjugate with each other and undergoes homo oligomerisation with ATG16L to form an 800 kDa complex called the Atg16L complex. This complex facilitates coupling or lipidation of LC3 to phosphatidylethanolamine (PE) and this ubiquitin-like conjugation system is a widely used marker for autophagy. However, the ATG 16L complex along with other ATGs like ATG 18 and ATG 21 prevent the premature cleavage of ATG8-PE by the cysteine protease, Atg4 until the autophagosome is deemed complete.
仅用于科研。不用于诊断过程。未经明确授权不得转售。
篇参考文献 (0)
生物信息学
蛋白别名: A16L1; APG 16-L1; APG16-like 1; APG16L beta; APG16L isoforms 1; atg16; ATG16 autophagy related 16-like 1; ATG16L1; Atg16L1 gamma; autophagy-related 16-like 1; autophagy-related 16-like 1 gamma; Autophagy-related protein 16-1; hCG_1817841; isoform 2 is encoded by transcript variant 2; unnamed protein product; WD repeat domain 30
基因别名: 1500009K01Rik; APG16L; ATG16A; ATG16L; ATG16L1; IBD10; UNQ9393/PRO34307; WDR30
UniProt ID: (Human) Q676U5, (Mouse) Q8C0J2
Entrez Gene ID: (Human) 55054, (Mouse) 77040, (Rat) 363278



